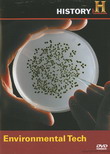

|
|
|

|
19,99 $
EONE ENTERTAINMENT
|
août 2008
|
|
29,99 $
In this eye opening program, Modern Marvels examines how some of the world's best minds are using today's most innovative technologies to help preserve and protect the planet. Learn how tongue-twis... » Lire la suite...
EONE ENTERTAINMENT
|
août 2008
|

|
116,99 $
The acclaimed American Experience series presents The Presidents Collection: ten 20th century presidential biographies that offer an intimate and compelling look at the men who have defined and re-... » Lire la suite...
Alliance Ent.-Paramount
|
août 2008
|

|
24,99 $
MONGREL
|
août 2008
|

|
19,99 $
VIVENDI
|
novembre 2010
|

|
25,99 $
NATIONAL GEOGRAPHIC
|
août 2008
|

|
21,99 $
*** Résumé en anglais seulement ***
The Vietnam War was one of the worst horrors of the second half of the 20th century and the causes behind it continue to baffle people to this day. How did it... » Lire la suite...
EONE ENTERTAINMENT
|
avril 2011
|

|
24,99 $
CPM DISTRIBUTION
|
mai 2008
|

|
21,99 $
Our children will inherit a legacy from a century of dramatic change – a legacy generated by a hundred years of technological and political hyperactivity. The beneficiaries of this legacy will undo... » Lire la suite...
EONE ENTERTAINMENT
|
avril 2011
|

|
21,99 $
Take the plunge into the deep and discover all that lies beneath the surface of the great, wide ocean. Mysteries of the Deep: Best of Undersea Explorers dips into the enigma of marine life and unco... » Lire la suite...
EONE ENTERTAINMENT
|
avril 2011
|

|
21,99 $
Now, you can enjoy the epic story of NASA and American space exploration like never before! This exciting and comprehensive five-DVD collectors' edition takes you on the adventure of a lifetime, a ... » Lire la suite...
EONE ENTERTAINMENT
|
avril 2011
|

|
24,99 $
Air power wins battles but land power wins wars. This is the story of the hardware that dominates the modern battlefield. Climb aboard the undisputed heavyweight “King of the Desert,” the mighty M1... » Lire la suite...
CPM DISTRIBUTION
|
mai 2008
|

|
24,99 $
From fighters to bombers and giant cargo ships, this is the inside story of nine history-making aircraft and the men and women who navigated them. Each episode highlights a particular airplane on a... » Lire la suite...
CPM DISTRIBUTION
|
mai 2008
|

|
24,99 $
This is the story of the weapons and seamen of the most powerful naval force in history. Go on board a virtual “city at sea” with the super carriers on patrol in hostile waters. Witness up close th... » Lire la suite...
CPM DISTRIBUTION
|
mai 2008
|

|
24,99 $
This new DVD collection takes a definitive, scientific look at the current state of the search for UFOs, documenting many sightings, which have been debunked and more importantly, bringing viewers ... » Lire la suite...
CPM DISTRIBUTION
|
mai 2008
|

|
21,99 $
EONE ENTERTAINMENT
|
avril 2011
|

|
16,99 $
In the beginning there was a great void…this is the story of everything that came after that. From the Big Bang to the most current research performed by the greatest minds in space exploration, th... » Lire la suite...
CPM DISTRIBUTION
|
mai 2008
|

|
24,99 $
Nearly 100 years have passed since the world was catapulted into one of the worst conflicts it had ever seen. World War I was dubbed the "Great War" and rightfully so. It was the first war to affec... » Lire la suite...
CPM DISTRIBUTION
|
mai 2008
|

|
24,99 $
Elephants...lions...rhinos...hippos...you never know what you’ll come across when you enter the kingdom of Wild Africa! Discover the wild like never before and develop a new affinity with nature wi... » Lire la suite...
CPM DISTRIBUTION
|
mai 2008
|

|
21,99 $
Known as the oasis of the sea, coral reefs are among the ocean’s most wondrous and mystical life forms. Take a voyage deep beneath the water in Oceans Alive, a 5-DVD exploration of the inner workin... » Lire la suite...
MADACY (PARADOX)
|
avril 2011
|

|
21,99 $
Marine biologists have long been fascinated with predators of the sea. From the majestic great white shark to the damsel fish, one of the smallest creatures in the ocean but also one of the fierces... » Lire la suite...
MADACY (PARADOX)
|
avril 2011
|

|
21,99 $
Marine biologists have long been fascinated with predators of the sea. From the majestic great white shark to the damsel fish, one of the smallest creatures in the ocean but also one of the fierces... » Lire la suite...
MADACY (PARADOX)
|
avril 2011
|

|
24,99 $
After years of shifty threats and menacing troop movements, World War II hit Europe with all its devious force; bringing with it an unimaginable level of depravity and destruction. It didn’t take l... » Lire la suite...
CPM DISTRIBUTION
|
juillet 2008
|

|
22,99 $
On September 1, 1939 Nazi Germany shocked the world when it rained bombs over Poland in the first Blitzkrieg. Two days later, on what came to be known as Black Sunday, Great Britain and France decl... » Lire la suite...
MADACY (PARADOX)
|
avril 2011
|

|
21,99 $
The war in the Pacific Theater during World War Two was unlike any ever fought. It was a savage, no holds barred conflict, fought in dense jungles and on barren volcanic islands. It covered tens of... » Lire la suite...
MADACY (PARADOX)
|
avril 2011
|
|
|
1449 article(s) au panier.
Renaud-Bray vous offre
les frais de livraison *
|